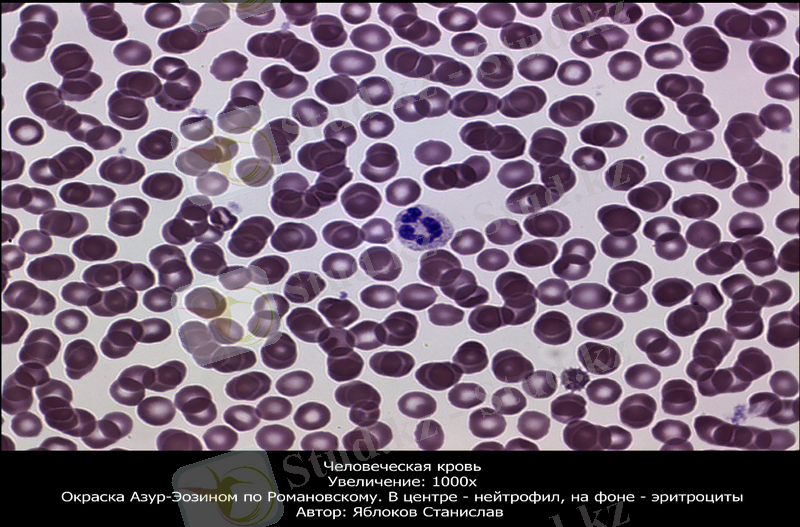
Slide 18

Гистологиялық препараттарды дайындау және бояу әдістері



Гистологиялық препараттарды жасау және бояу әдістері

Жоспары:
Гистологиялық препараттар.
Гистологиялық препараттарды дайындаудың негізгі кезеңдері.
Гистологиялық кесінділерді бояған кезде ұстанатын ережелер.
Препараттарды бояу тәсілдері.
Пайдаланылған әдебиеттер.

Гистологиялық препараттар
бұл арнайы гистологиялық бояғыштармен боялған ағзалар, тіндер немесе жасушалар кесінділері.
Гистологиялық препараттар - микроскопиялық зерттеулерде пайдаланылады.

Гистологиялық препараттар зерттеу мақсатына байланысты бөлінеді:

Жақсы дайындалған гистологиялық препарат мына көрсетілген нұсқауларға сай болуы қажет:
Оны қамтамасыз ету үшін:
-дер кезінде зерттелетін материалды алу және фиксациялау;
-кесінділердің сапасы мен өңдеу шаралары;
- зерттелетін препаратқа сәйкес бояуды қолдану;

Гистологиялық препараттарды дайындаудың негізгі кезеңдері мыналар:

Кескіндерді бояу.

Гистологиялық кесінділерді бояған кезде жақсы нәтиже алу үшін, төмендегі ережелерді ұстану қажет:


Бояу алдында жұмыс орнын дайындап алады, үстелдегі артық құралдарды алып тастап, микроскопты орнатады.
Белгілі бір ерітінді түрлеріне байланысты ыдыстарды ретпен қойып, жапқыш шыныларды және тағы басқа құрал жабдықтарды даярлайды.
Кейін ғана барып бояуға кіріседі.
Бояу әдістері.

Парафинді кесіндінің мөлдірлігі төмен болғандықтан, олар неғұрлым күрделі өңдеуді қажет етеді.

1. Кесінділерді гематоксилин-эозинмен бояу тәсілі
Бұл әдіс гистологиялық тәжірибеде кеңінен қолданылып келе жатыр. Бояуды белгілі бір ретпен орындау керек. Бояу нәтижесі, әдіспен қатар кесіндінің құрамына да байланысты. Қандай бояу әдісі қолданылса да, ең бірінші міндет парафинді еріту.


Гематоксилин - табиғи бояу, ол суда, спиртте және глицеринде жүргізіледі. Гематоксилин ерітіндісі негіздік қасиеттерге ие, ядро құрылымдарын анық көрсетеді. Бірақ гематоксилиннің өзі боямайды, бояушы оның өнімі - гематейн.

Эозин - жасанды бояу, суда не спиртте ериді, қышқылдық қасиетке ие, торша цитоплазмасын қызғылт түске бояйды. Гематоксилинмен боялған кесіндіні дистилденген суда жақсылап шайып, үстіне эозин ерітіндісін тамызады. Бояу уақытының мағынасы зор, мерзімі 1-4-5 минутқа дейін созылады.

2. Темір гематоксилинмен бояу.
- Құрылымдар қоңыр-сұр түске ие болады.
- Ядро құрылымдары, жасуша шекаралары, бұлшықет талшықтары жақсы анықталған.

Дәнекер тін мен қан жасушаларының бояу әдістері

Препарат-иттің аш ішегі
Гематоксилин-эозинмен боялған
Суретте біз ішектің ішкі бетін (1) көреміз.
а) жасуша ядролары (2) - базофильді және гематоксилинмен күлгін түске боялған. б) Цитоплазма (3) оксифилді және эозинмен қызғылт түске боялған.
Препарат-ақ майлы тін.
Судан III-гематоксилинмен бояу.
а) препараттағы май жасушалары үлкен май тамшыларымен толтырылған (1), Олар судан ІІІ ашық-қызғылт сары түске боялған.
б) гематоксилинмен күлгін түске боялған жасуша ядролары (2) .

Пайдаланылған әдебиеттер:
1. Гистология: Оқу құралы төрт бөлімді/ Ж. О. Аяпова. Алматы: «Кітап» баспасы. - 2005. - 285 б.
2. Гистология, цитология және эмбриология атласы медицина жоғары оқу орындарының студенттеріне арналған. /Р. Б. Абильдинов, Ж. О. Аяпова, Р. И. Юй. - Алматы: «Эффект» баспасы, 2006. - 411 б.
3. Гистология, цитология және эмбриология атласы: медициналық жоғары оқу орындарының студенттеріне арналған оқу құралы. / П. Қазымбет, М. Рысұлы, Ж. Б. Ахметов. - Астана, 2005. - 400 б.
4. Гистология: Оқу құралы. Ажаев С. А. Төрт бөлімді. Кентау: Еркін и К - ХХI, 2004.

Назарыңызға көп рахмет!
- Іс жүргізу
- Автоматтандыру, Техника
- Алғашқы әскери дайындық
- Астрономия
- Ауыл шаруашылығы
- Банк ісі
- Бизнесті бағалау
- Биология
- Бухгалтерлік іс
- Валеология
- Ветеринария
- География
- Геология, Геофизика, Геодезия
- Дін
- Ет, сүт, шарап өнімдері
- Жалпы тарих
- Жер кадастрі, Жылжымайтын мүлік
- Журналистика
- Информатика
- Кеден ісі
- Маркетинг
- Математика, Геометрия
- Медицина
- Мемлекеттік басқару
- Менеджмент
- Мұнай, Газ
- Мұрағат ісі
- Мәдениеттану
- ОБЖ (Основы безопасности жизнедеятельности)
- Педагогика
- Полиграфия
- Психология
- Салық
- Саясаттану
- Сақтандыру
- Сертификаттау, стандарттау
- Социология, Демография
- Спорт
- Статистика
- Тілтану, Филология
- Тарихи тұлғалар
- Тау-кен ісі
- Транспорт
- Туризм
- Физика
- Философия
- Халықаралық қатынастар
- Химия
- Экология, Қоршаған ортаны қорғау
- Экономика
- Экономикалық география
- Электротехника
- Қазақстан тарихы
- Қаржы
- Құрылыс
- Құқық, Криминалистика
- Әдебиет
- Өнер, музыка
- Өнеркәсіп, Өндіріс
Қазақ тілінде жазылған рефераттар, курстық жұмыстар, дипломдық жұмыстар бойынша біздің қор #1 болып табылады.



Ақпарат
Қосымша
Email: info@stud.kz